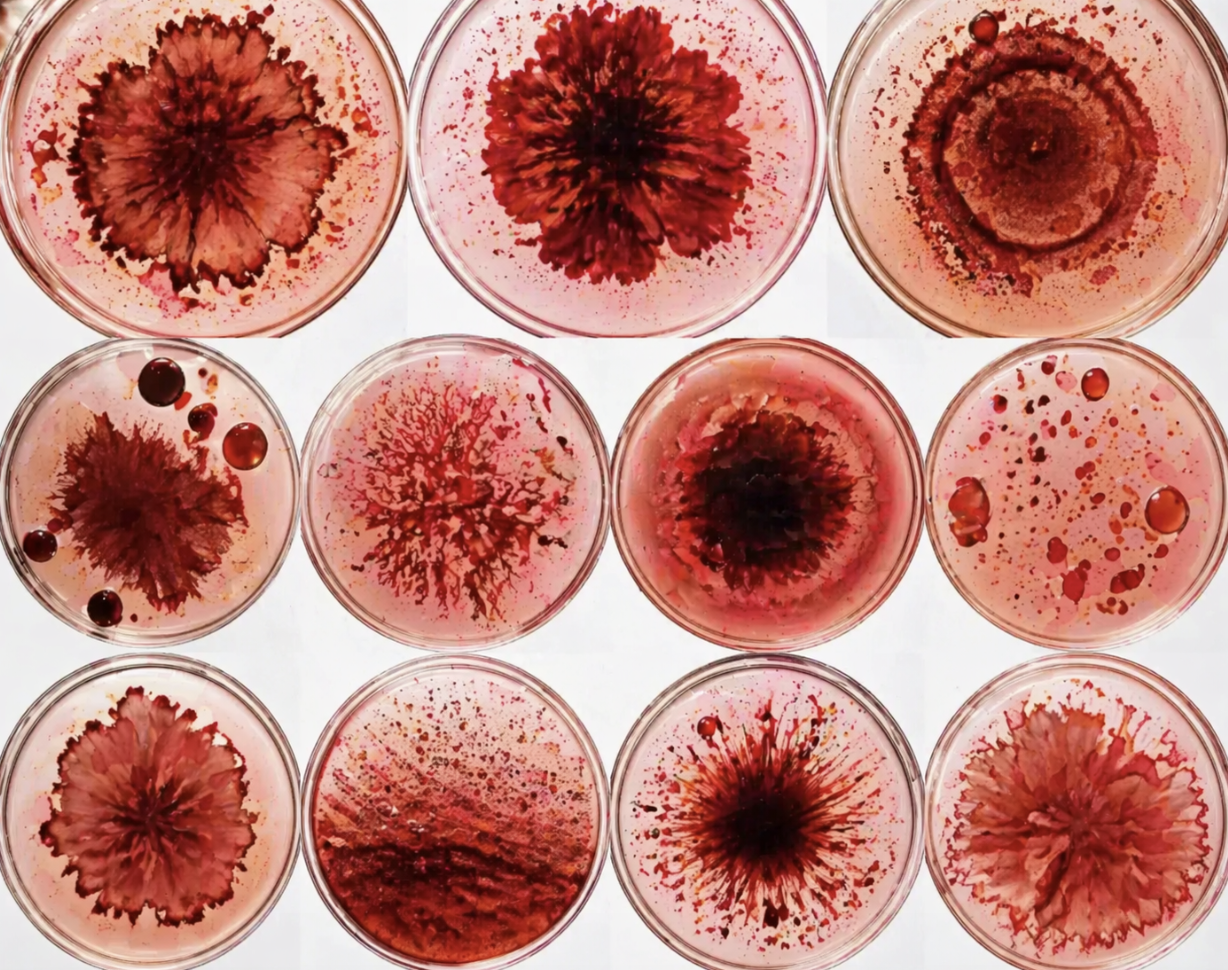

Unlocking the diagnostic potential of menstrual blood
A non-invasive way to access health data, grounded in biology and clinical validation.

“Menstrual blood is not waste. It is a complex and unique biological sample with both endometrial and systemic components.
Our work focuses on developing and validating approaches to generate clinically meaningful insights from it, opening up access to data that can improve diagnosis and healthcare outcomes for women.”
Dr. Amy Whitbread
Chief Scientific Officer

Changing how women’s health is understood
Women are diagnosed years later than men across more than 700 diseases.
Women were underrepresented in clinical research for decades. Much of our medical knowledge is still based on incomplete data. This still shapes healthcare today. We are still missing data where it matters most.
Menstrual blood provides non-invasive access to biological information and captures insights directly from the uterus and reproductive tract.

How we turn biology into infrastructure
Understanding the biology
What is present and what can be measured.
Validating the signal
Comparison to standard diagnostics, clinical studies across defined cohorts, and reproducible measurement methods.
Applying it
Routine health insights, reproductive health monitoring, and future diagnostic applications.
From exclusion to evidence
1977
Women of childbearing potential excluded from early clinical trials.
Systematic gaps in data begin.

2020
Sex and gender analysis required in research frameworks.
Recognition of the gender data gap.

2024
theblood demonstrates the feasibility of measuring biomarkers in menstrual blood as a non-invasive approach to monitoring vitamin levels (Journal of Clinical Medicine).
Contribution to emerging research in menstrual blood diagnostics.
Now
Development of menstrual blood–based diagnostic tests.
Coming Soon

1993
Inclusion of women in clinical research mandated.
Representation improves, but gaps remain.
2022
theblood begins clinical research on menstrual blood.
Research focused on women’s biology.
2025
Partnership with SGS to advance analytical and clinical validation.
Focus on validated menstrual blood diagnostics.



Menstrual blood offers a unique biological window into the uterus.
It is more than just blood.
It contains signals from both the uterine environment and systemic circulation.
Endometrial Cells
Cells shed from the functional layer of the endometrium, including stromal and epithelial cells, reflecting cyclical tissue breakdown, repair, and endometrial function.
Cervicovaginal components
Cervical mucus, vaginal secretions, and associated microbiota, contributing additional signals related to mucosal biology and local immune interactions.
Stem and progenitor cells
Endometrial-derived stem and progenitor cells reflecting ongoing tissue renewal and repair processes.
Immune cells
A dynamic population of leukocytes, including macrophages, neutrophils, uterine natural killer (uNK) cells, and T cells, involved in inflammation, tissue breakdown, and regeneration across the menstrual cycle.
Blood-derived components
Components derived from peripheral blood, including red blood cells, hormones, metabolites, and circulating proteins, reflecting broader physiological and endocrine status.
Proteins and signalling molecules
A complex mixture of proteins, including cytokines, growth factors, and other signalling molecules involved in inflammation, immune regulation, and tissue remodelling.
Together, these components provide access to both uterine and systemic biology in a single sample.
Where we focus first

Standardized collection and handling

Robust analytical methods

Clinical validation

Reliable, interpretable, and clinically usable results
The Pipeline
Preclinical
Clinical
Launch
Hormone & metabolic testing



Inflammation insights



Disease-specific diagnostics



Advancing women’s health through menstrual blood
Menstrual blood testing offers a non-invasive way to access health data and insights. It creates the potential for earlier insights, reduces barriers to testing, and generates data that better reflects women’s biology.

More accessible health data for women

Data that better reflects female biology

Improved healthcare outcomes for women
Built on science
Our work is grounded in multidisciplinary expertise across diagnostics, clinical research, and women’s health.
We work with clinical partners and accredited laboratories to ensure our methods meet scientific and regulatory standards.

